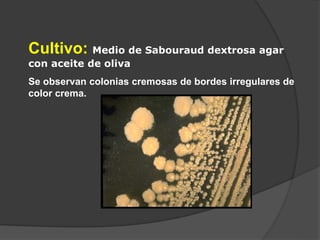
Cultivo: Medio de Sabouraud dextrosa agar
con aceite de oliva
Se observan colonias cremosas de bordes irregulares de
color crema.

La pitiriasis versicolor es una infección superficial crónica de la piel causada por la levadura Malassezia furfur. La tiña capitis es una micosis superficial causada principalmente por Microsporum canis o Trichophyton tonsurans que afecta el cuero cabelludo. Las dermatofitosis o tiñas son infecciones superficiales de la piel, pelo y uñas causadas por hongos del género Trichophyton, Microsporum y Epidermophyton.